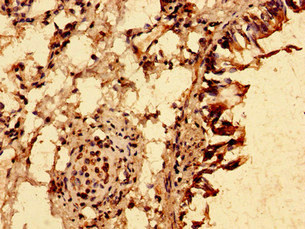
CSB-PA024457LA01HU

TRIM21
TRIM21,即三結(jié)構(gòu)域蛋白21,別名Ro52、Ssa1,屬于三結(jié)構(gòu)域蛋白家族成員之一,主要在細(xì)胞內(nèi)發(fā)揮作用。
TRIM21的作用機制涉及其作為E3泛素連接酶的功能,依賴于E2酶如UBE2D1、UBE2D2、UBE2E1和UBE2E2,與UBE2D2形成泛素連接酶復(fù)合物,泛素化USP4、IKBKB及其自身,還與基于cullin-RING的SCF E3連接酶復(fù)合物相關(guān),介導(dǎo)CDKN1B泛素化。TRIM21是細(xì)胞內(nèi)抗體效應(yīng)器,在細(xì)胞內(nèi)抗體介導(dǎo)的蛋白降解途徑中發(fā)揮作用,識別Fc結(jié)構(gòu)域并結(jié)合抗體標(biāo)記的非包膜病毒,通過自泛素化或泛素化輔助因子,將病毒引導(dǎo)至蛋白酶體進(jìn)行降解。此外,TRIM21還參與固有免疫反應(yīng),通過影響細(xì)胞內(nèi)PRR介導(dǎo)的信號傳導(dǎo),積極或消極地調(diào)節(jié)抗病毒反應(yīng)。
TRIM21的功能異常與多種自身免疫性疾病相關(guān),如系統(tǒng)性紅斑狼瘡等。
熱銷產(chǎn)品
Recombinant Human E3 ubiquitin-protein ligase TRIM21 (TRIM21) (CSB-BP024457HU)
驗證數(shù)據(jù)

(Tris-Glycine gel) Discontinuous SDS-PAGE (reduced) with 5% enrichment gel and 15% separation gel.
TRIM21 Antibody (CSB-PA024457LA01HU)
驗證數(shù)據(jù)

Western Blot
Positive WB detected in: A549 whole cell lysate
All lanes: TRIM21 antibody at 2μg/ml
Secondary
Goat polyclonal to rabbit IgG at 1/50000 dilution
Predicted band size: 55, 46 kDa
Observed band size: 55 kDa
Immunohistochemistry of paraffin-embedded human lung tissue using CSB-PA024457LA01HU at dilution of 1:100
TRIM21 Antibodies
TRIM21 for Homo sapiens (Human)
| 產(chǎn)品貨號 | 產(chǎn)品名稱 | 種屬反應(yīng)性 | 應(yīng)用類型 |
|---|---|---|---|
| CSB-PA024457GA01HU | TRIM21 Antibody | Human,Mouse,Rat | ELISA,WB,IHC |
| CSB-PA173569 | TRIM21 Antibody | Human | ELISA,IHC |
| CSB-PA548244 | TRIM21 Antibody | Human | ELISA,WB |
| CSB-PA024457LA01HU | TRIM21 Antibody | Human | ELISA, WB, IHC |
| CSB-PA024457LB01HU | TRIM21 Antibody, HRP conjugated | Human | ELISA |
| CSB-PA024457LC01HU | TRIM21 Antibody, FITC conjugated | Human | |
| CSB-PA024457LD01HU | TRIM21 Antibody, Biotin conjugated | Human | ELISA |
TRIM21 for Mus musculus (Mouse)
| 產(chǎn)品貨號 | 產(chǎn)品名稱 | 種屬反應(yīng)性 | 應(yīng)用類型 |
|---|---|---|---|
| CSB-PA733816LA01MO | Trim21 Antibody | Mouse | ELISA |
| CSB-PA733816LB01MO | Trim21 Antibody, HRP conjugated | Mouse | ELISA |
| CSB-PA733816LD01MO | Trim21 Antibody, Biotin conjugated | Mouse | ELISA |
TRIM21 Proteins
TRIM21 Proteins for Homo sapiens (Human)
| 產(chǎn)品貨號 | 產(chǎn)品名稱 | 來源 |
|---|---|---|
| CSB-YP024457HU | Recombinant Human E3 ubiquitin-protein ligase TRIM21 (TRIM21) | Yeast |
| CSB-EP024457HU | Recombinant Human E3 ubiquitin-protein ligase TRIM21 (TRIM21) | E.coli |
| CSB-MP024457HU CSB-EP024457HU-B |
Recombinant Human E3 ubiquitin-protein ligase TRIM21 (TRIM21) | Mammalian cell In Vivo Biotinylation in E.coli |
| CSB-BP024457HU | Recombinant Human E3 ubiquitin-protein ligase TRIM21 (TRIM21) | Baculovirus |
| CSB-EP024457HUc7 | Recombinant Human E3 ubiquitin-protein ligase TRIM21 (TRIM21) | E.coli |
TRIM21 Proteins for Mus musculus (Mouse)
| 產(chǎn)品貨號 | 產(chǎn)品名稱 | 來源 |
|---|---|---|
| CSB-YP733816MO CSB-MP733816MO CSB-EP733816MO-B |
Recombinant Mouse E3 ubiquitin-protein ligase TRIM21 (Trim21) | Yeast Mammalian cell In Vivo Biotinylation in E.coli |
| CSB-EP733816MO | Recombinant Mouse E3 ubiquitin-protein ligase TRIM21 (Trim21) | E.coli |
| CSB-EP733816MOa0 | Recombinant Mouse E3 ubiquitin-protein ligase TRIM21 (Trim21) | E.coli |
TRIM21 Proteins for Bos taurus (Bovine)
| 產(chǎn)品貨號 | 產(chǎn)品名稱 | 來源 |
|---|---|---|
| CSB-YP768741BO CSB-EP768741BO CSB-BP768741BO CSB-MP768741BO CSB-EP768741BO-B |
Recombinant Bovine E3 ubiquitin-protein ligase TRIM21 (TRIM21) | Yeast E.coli Baculovirus Mammalian cell In Vivo Biotinylation in E.coli |











